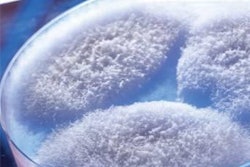
Fumonisins are harmful fungal metabolites mainly produced by Fusarium proliferatrum (shown above), and F verticilloides.

Lallemand Animal Nutrition and Texas A&M Agrilife Research have announced a collaboration to be launched at the McGregor Research Center in McGregor, TX. Lallemand Animal Nutrition has established partnerships worldwide as part of its Research Centers of Excellence program, to “Forward” the development and innovation of microbial solutions.
“We’re at the forefront of providing modern yeast, bacteria and microbial solutions, and collaborative partnerships,” says Mathieu Castex, PhD., Global Research and Development Director, Lallemand Animal Nutrition. “Our Centers of Excellence provide the opportunity to evaluate our technologies in real-life situations. This collaboration is one of two dedicated to product applications for beef, dairy and small ruminant animals. The work completed at these locations focuses on continuously documenting the mode of action, biomarkers of efficacy and benefits of existing yeast and bacteria strains. The researchers also are working toward a better understanding of the microbial ecosystems, solutions and applications to support sustainable animal production, Dr. Castex adds.
“In particular, we are aiming to document microbial solutions that can help to answer the modern challenges of dairy and beef production ─ maintaining optimal production while enhancing animal well-being,” he says.
Kerry Barling, DVM, PhD, Global Manager of Beef technology with Lallemand helped select Texas A&M AgriLife Research for this partnership based on its vision for supporting animal agriculture.
“The research completed at the McGregor facility, along with our other Ruminant Centers of Excellence, will be a combination of strain selection; identification and characterization; as well as in vitro and in vivo testing,” Dr. Barling says. “With this new partnership, we can complete more field validation work and real-life monitoring with a GrowSafe System to measure individual animal feed intake and